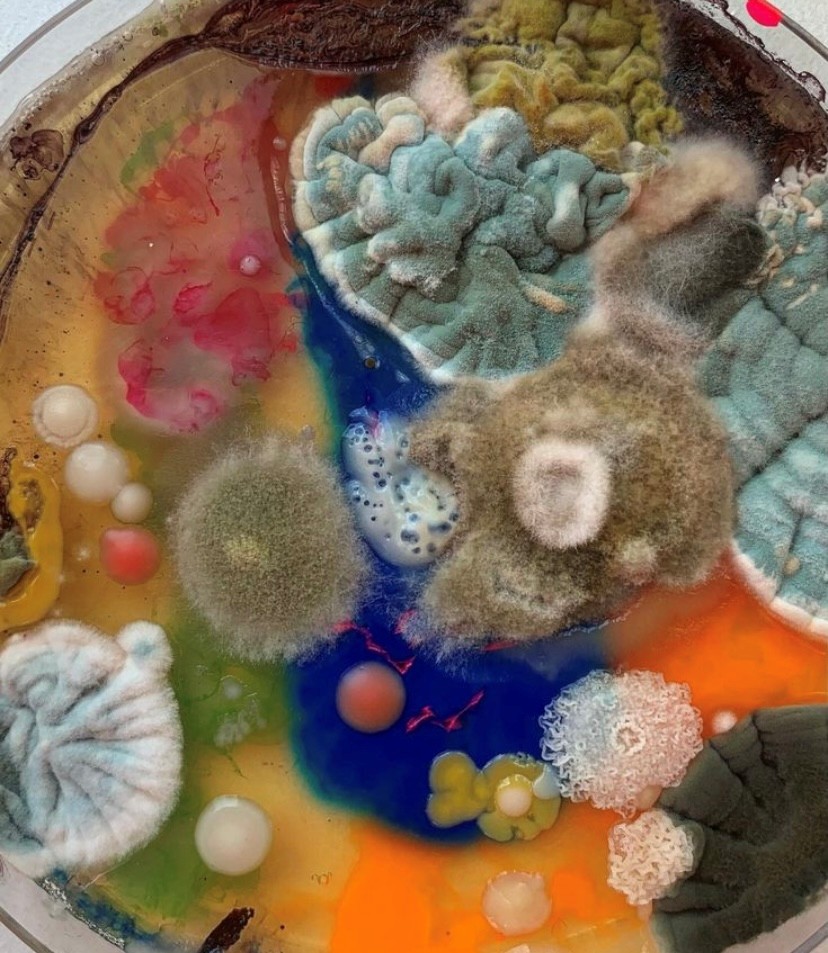

Residenzförderung 2025 des Fonds Darstellende Künste in Kooperation mit flausen+ / 2025 Residency funding programme from the Performing Arts Fund (Fonds Darstellende Künste) in cooperation with flausen+
ROTEM WEISSMAN
PRESERVE – CALL FOR ATTENTION / Tanz / PERFORMANCE
BERLIN
Residenzaufenthalt: 22. BIS 31.07.2025
PRESERVE – CFA ist ein choreografisches Forschungsprojekt, das sich mit extremen Daseinszuständen zwischen Wachstum und Verfall sowie der kollektiven Betäubung befasst, die uns nach der aktuellen globalen Krise erfasst hat. Die aktuelle Recherche von Rotem Weissman untersucht den Kampf mit dem Überwältigenden in einer atemlosen, beschleunigten und amplifizierten Gesellschaft. Wie erkennen wir ein Notsignal, einen Hilferuf? Was fordert unsere Aufmerksamkeit, wenn die Sinneseindrücke überhandnehmen und der Körper abschaltet, um die Wahrnehmung zu blockieren und die Informationsflut abzuschirmen? Welche Katastrophen werden als außerhalb unserer Kontrolle wahrgenommen, welche nicht und warum? Wie reagiert der Körper in Zuständen von Trauma und Extremen? Wie präsent ist die Frage nach kollektiver Macht und Verantwortung?
PRESERVE – CFA is a choreographic research project that deals with extreme states of existence between growth and decay, as well as the collective numbness that has overcome us in the wake of the current global crisis. Rotem Weissman’s current research explores the struggle with the overwhelming in a breathless, accelerated and amplified society. How do we recognise a distress signal, a cry for help? What demands our attention when sensory impressions take over and the body shuts down to block perception and shield itself from the flood of information? Which disasters are perceived as beyond our control, which are not, and why? How does the body react in states of trauma and extremes? How present is the question of collective power and responsibility?
Choreografie & Performance: Rotem Weissman
Performance & Künstlerische Mitarbeit: Susanna Ylikoski
Dramaturgie: Maya Weinberg
Komposition / Sound: Roi Becker
Ein Projekt in der Residenzförderung des Fonds Darstellende Künste in Kooperation mit flausen+
Gefördert vom Fonds Darstellende Künste aus Mitteln des Beauftragten der Bundesregierung für Kultur und Medien.
Hier gehts zur Website.